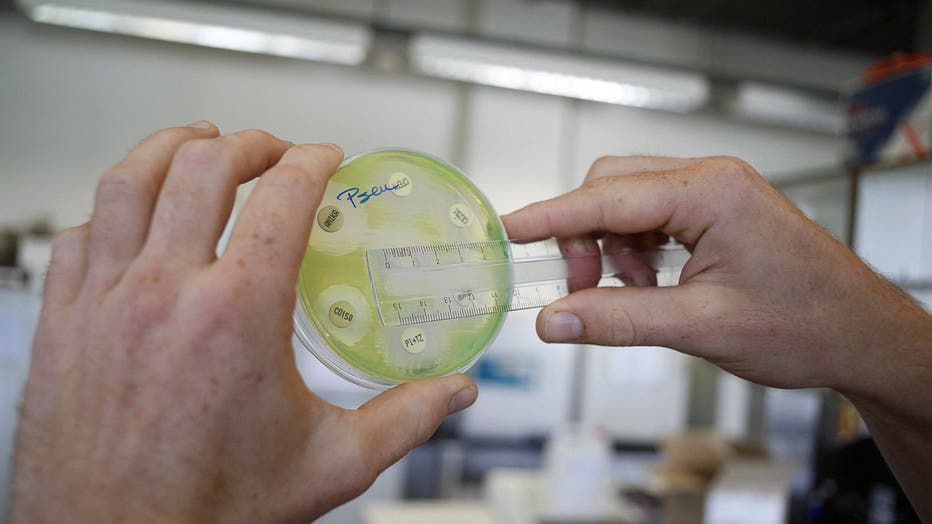

'Nightmare bacteria' cases on the rise in US, CDC report finds


Flesh-eating bacteria found along East Coast, Gulf states
Health officials are warning beachgoers to be cautious in coastal waters after reports of deadly infections caused by Vibrio vulnificus, a flesh-eating bacteria that thrives in warm seawater and brackish environments. The bacteria is considered the most dangerous of more than a dozen Vibrio species. While cases remain relatively rare, Vibrio vulnificus infections are highly lethal, killing about one in five people who become infected, according to the Centers for Disease Control and Prevention. LiveNOW from FOX's Christy Matino breaks down the latest with Dr. Tyler Evans, CEO and co-founder of Wellness and Equity Alliance.
Infectious disease doctors are sounding the alarm after a new CDC report found that drug-resistant "nightmare bacteria" infections rose drastically in the U.S. between 2019 and 2023.
The Centers for Disease Control and Prevention article was published Monday in the Annals of Internal Medicine.
What are NDM bacteria?
What we know:
In recent years, the CDC has drawn attention to " nightmare bacteria " resistant to a wide range of antibiotics. That includes carbapenems, a class of antibiotics considered a last resort for treatment of serious infections.
Bacteria that are difficult to treat due to the so-called NDM gene primarily drove the increase in infections, the report found.
FILE - A researcher holding a petri dish with a culture at a microbiology lab (Photo by JORGE DIRKX/BELGA/AFP via Getty Images)
Only two antibiotics work against those infections, and the drugs are expensive and must be administered through an IV, researchers said.
RELATED: What is leucovorin? FDA to relabel drug for autism treatment
Antimicrobial resistance occurs when germs such as bacteria and fungi gain the power to fight off the drugs designed to kill them. The misuse of antibiotics was a big reason for the rise — unfinished or unnecessary prescriptions that didn’t kill the germs made them stronger.
What we don't know:
The CDC’s count is only a partial picture.
Many states are not fully testing and reporting cases. Even in states that do, cases tend to be among hospital patients sick enough to warrant special testing. Many hospitals also aren’t able to do the testing needed to detect certain forms of genetic resistance.


CDC advisory panel changes vaccine recommendations
KFF's Dr. Jennifer Kates joins LiveNOW's Mike Pache to discuss a CDC advisory panel's vote to restrict COVID-19 vaccine recommendations to people older than 65 and those with underlying medical conditions.
The CDC researchers did not have data from some of the most populous states, including California, Florida, New York and Texas, which means the absolute number of U.S. infections "is definitely underestimated."
Researchers drew data from 29 states that do the necessary testing and reporting of carbapenem-resistant bacteria.
What they're saying:
"The rise of NDMs in the U.S. is a grave danger and very worrisome," said David Weiss, an Emory University infectious diseases researcher, in an email.
A researcher not involved in the study said the increase is probably related to the COVID-19 pandemic.
"We know that there was a huge surge in antibiotic use during the pandemic, so this likely is reflected in increasing drug resistance," said Dr. Jason Burnham, a Washington University researcher, in an email to The Associated Press.
By the numbers:
Infection rates from drug-resistant "nightmare bacteria" rose almost 70% between 2019 and 2023.
They counted 4,341 cases of carbapenem-resistant bacterial infections from those states in 2023, with 1,831 of them the NDM variety. The researchers did not say how many of the infected people died.
The rate of carbapenem-resistant infections rose from just under 2 per 100,000 people in 2019 to more than 3 per 100,000 in 2023 — an increase of 69%. But the rate of NDM cases rose from around 0.25 to about 1.35 — an increase of 460%, the authors said.
The backstory:
Bacteria with the gene were once considered exotic, linked to a small number of patients who received medical care overseas. Though the numbers are still small, the rate of U.S. cases jumped more than fivefold in recent years, the researchers reported.
Why you should care:
It’s likely many people are unrecognized carriers of the drug-resistant bacteria, which could lead to community spread, the CDC scientists said.
That may play out in doctors’ offices across the country, as infections long considered routine — like urinary tract infections — could become harder to treat, said Dr. Maroya Walters, one of the report’s authors.
The Source: This report includes information from The Associated Press and the U.S. Centers for Disease Control and Prevention.

